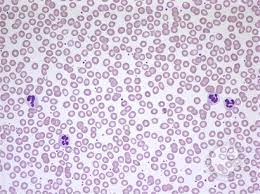
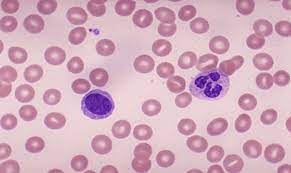

1 Overview of Hematopoiesis
Background knowledge you need to have mastered PRIOR to Session 1/Day 1
To understand this course and lectures, you first must understand the composition of blood and the specific hematopoietic tissues. This has already been covered in your Fundamentals of Medical Science and Research course. Specifically, this was covered in the histology of blood class taught in FMR. If you need a refresher/review, Chapter 1 of your textbook for this blood and cancer course (Pathophysiology of Blood Disorders), covers this nicely and is a quick 11-page read.
Learning Objectives
- Recognize the cells present in peripheral blood and bone marrow by morphologic review.
- Describe the key properties and functions that define a a hematopoietic stem cell.
- Describe the hierarchical organization of hematopoiesis and the cell intrinsic and extrinsic signals that inform cellular differentiation, including identifying the common hematopoietic growth factors and understanding their clinical utility.
- Describe the concept of clonal heterogeneity in hematopoietic progenitors and how the acquisition of somatic mutations can lead to cancer (e.g. leukemia).
USMLE Content Descriptors: Transplantation, cell tissue/structure and function, disorders of hemoglobin, heme or membrane, cytopenias.
Throughout the course pack we will specify which portions of the text book (Pathophysiology of Blood Disorders, Aster and Bunn) are required and we will also point out portions of the text book that are optional but which may be helpful.
Overview of Hematopoiesis
Here we cover hematopoiesis, which is the process of production of cells normally found in the peripheral/circulating blood in our body: Red blood cells (RBCs), White blood cells (WBCs) and Platelets. You will learn about peripheral blood smears. You will learn to recognize RBCs and WBCs and platelets on peripheral blood smears. You will also learn to recognize a variety of cells present in the bone marrow. The bone marrow is where all blood cells originate. There you will find mature RBCS, WBCs and platelets, platelet-producing cells called megakaryocytes, and the many more immature precursor bone marrow cells from which the mature blood cells develop. You will learn about the hierarchical organization of hematopoiesis and the intrinsic and extrinsic cell signals that inform cellular differentiation in the bone marrow. This will include identifying the common hematopoietic growth factors and understanding their clinical utility. Lastly, we will discuss the concept of clonal heterogeneity in the hematopoietic progenitor cells and how the acquisition of somatic gene mutations can lead to cancer (e.g. leukemia).
Peripheral blood cells:

Before we talk about bone marrow production of peripheral blood cells, we need to understand what peripheral blood cells are. These cells are the final mature cells/platelets produced by the bone marrow that are found in our circulating blood. Peripheral blood cells include the white blood cells which help fight infections (WBCs), the red blood cells that carry oxygen (RBCs), and the platelets, which are specialized cellular fragments that help our blood clot. Peripheral blood cells are measured in patients in a test we call a CBC—Complete blood count. A complete blood count measures Red blood cells in a variety of ways, and you will see these reported as CBC results as follows:
Red Blood Cell indices reported on a routine CBC:
RBC count: Measure of how many red blood cells are present in the blood x 10^6/ul
Hematocrit (HCT): Percentage of whole blood that is red blood cells. (This can be measured in a spun tube, but more recently is calculated by a CBC machine.)
Hemoglobin (Hgb): a measured amount reflecting hemoglobin concentration. Noted, generally hemoglobin number (different unit of measure) is about 1/3 of the hematocrit number.
Mean Cell Volume (MCV): how large a red blood cell is (normal cells have a normal MCV. Diseases of RBCs can result in alterations in MCV in some situations, and we’ll cover this later).
Red Cell distribution Width (RDW): How much the red cells vary in size in a given patient (are cells uniformly one size or do they vary in size in a given patient).
Mean Cell Hemoglobin/MCH: (another calculated parameter, not directly measured)
Mean Cell Hemoglobin Concentration/MCHC: (another calculated parameter, not directly measured).
Reticulocyte count: Newest/freshest RBCs, which still have a bit of mRNA present, and indicate whether bone marrow RBC production is revved up.
CBC also give you a total White blood cell (WBC) count and a total platelet count.
Frequently included with a CBC is a white blood cell differential, aka differential or “diff”, that tells you the different types of white blood cells (WBCs) and gives you the numbers of these different white blood cells (neutrophils, lymphocytes, macrophages, eosinophils, basophils, bands) in absolute numbers and in percentages of the total white blood cell count. (Note, doctors sometimes have to order this differential separately as not all labs include a differential with a standard CBC order.)
It is helpful to know normal ranges for RBCs (the RBC count, the hematocrit, and the hemoglobin), as well as a generally understanding of what is normal for WBCs and platelets. It is also helpful to understand the shorthand nomenclature for how physicians write out the basic results of a patient’s CBC (in the old days we would write this stuff in the patient’s paper chart).
Lastly, it is important to know that automated CBC machines can make mistakes based upon other findings:
- Falsely elevated Hemoglobin (Hgb) can be caused by a high WBC, a lipemic sample, precipitated monoclonal proteins causing turbidity.
- Falsely decreased RBCs can be seen in certain settings, such as the presence of a cold agglutinin (an antibody that binds to red blood cells at temperatures below body temperatures and causes the cells to agglutinate such that the CBC machine measures a clump of RBCs as one cell).
- A falsely elevated MCV can be seen sometimes, such as with hyperglycemia and RBC swelling.
In any part of a patient evaluation of blood counts, it is also helpful to look at the blood smear. Realistically, as clinicians, you won’t do this often (unless you are a hematopathologist), but for the purposes of this course, you do need to understand how a blood smear is made, as you will see pictures of blood smears during this course. This was covered in your Fundamentals of Medical Science and Research course and is briefly reviewed in today’s lecture.
Why do we need to understand blood cells and how the bone marrow produces them? The answer is that blood is a high turnover tissue, cells are constantly being used/recycled….
Lifespan of normal peripheral blood cells circulating in blood:
- RBCs are produced constantly by the bone marrow, live for about 120 days (unless there are problems causing shorter RBC survival such as hereditary spherocytosis), and then are recycled by the spleen.
- Neutrophils (AKA Granulocytes/AKA PMNs) live for 12 hours to several days.
- Platelets live about 9-12 days.
- Lymphocytes live up to a month (most)
Our bone marrow is amazing! It produces 200 billion red blood cells a day, 10 billion white cells per day, and 400 billion platelets a day. These cells are critical for our survival. If the bone marrow doesn’t make these cells, we will either die from lack of oxygen (lack of red cells to carry oxygen to tissues), die from bleeding (lack of platelets) or die from infection (lack of WBCs).
Hematopoiesis: The Process of Blood Cell Production
Optional textbook reading: Chapter 2 Hematopoiesis (Section on Hematopoietic stem cells and progenitors)
Blood cell production occurs predominantly in the bone marrow.
Blood cell production is amazing. In addition to the billions of cells produced daily, as above, normal/healthy bone marrow can increase cellular production of cells in response to increased demand—such as increased red cell production in the setting of active bleeding, increased WBC production in response to infection, etc.
Also fascinating about blood cell production is that ALL HEMATOPOIETIC LINEAGES ARE DERIVED FROM ONE COMMON PROGENITOR CELL. This unique cell is called the Hematopoietic Stem Cell (HSC).
Another depiction of Hematopoiesis with more detail:
Hematopoiesis Overview summary key points:

All blood cells are derived from a common progenitor cell. This unique cell is called the Hematopoietic Stem Cell (HSC).
These stem cells divide either by asymmetric replication (one daughter cell retains its self-renewing capacity while the 2nd daughter cell enters a differentiation pathway) or by stochastic differentiation (balance between stem cell divisions that generate either two self-renewing stem cells or two daughter cells that differentiate).
As stem cells differentiate, they will differentiate into different cell lines either of the myeloid or lymphoid cell type:
Common myeloid progenitor cells:
Megakaryoblasts: These blast cells are progenitor cells that will differentiate into megakaryocytes, which produce platelets, which are needed to plug holes in capillaries and (platelet plugs) and are involved in activating the clotting cascade.
Proerythroblasts: These blast cells are progenitor cells that will differentiate into erythrocytes, AKA red blood cells that carry oxygen.
Myeloblasts: These blast cells are progenitor cells that will differentiate further to basophilic promyelocytes (which eventually become basophils, a type of myeloid white blood cell), neutrophilic promyelocytes (which eventually become neutrophils, another type of myeloid white blood cell that mainly fight bacterial infections), eosinophilic promyelocytes (which eventually become eosinophils, another type of myeloid white blood cell that is heavily involved in fighting parasitic infections), or monoblasts (another type of myeloid white blood cell that eventually becomes a monocyte in peripheral blood—monocytes further differentiate into macrophages and dendritic cells when they go into tissues, to help fight infections in tissues).
Common lymphoid progenitor cell:
Lymphoblasts: These blast cells are progenitor cells that will differentiate further into lymphocytes. Lymphocytes are further divided into B-cells (lymphocytes that mature in bone marrow) and T-cells (lymphocytes that further mature in the thymus) and Natural killer cells. There is also a lymphoid dentritic cell, but we don’t discuss this further other than to acknowledge its existence.

Note that all blasts (which are rarely seen in normal bone marrow) look the same, but as the cells start to further differentiate and mature, we can see these cells maturing in bone marrow and can pick them out. The picture below, for example, shows maturing red blood cells from the BFU-E stage. On bone marrow testing, we can’t identify the BFU-E or CFU-E cells (or the common myeloid progenitor). However, we can pick more differentiated proerythroblasts and their subsequent offspring.
Also, even though early blasts look the same morphologically, as they differentiate into common myeloid and common lymphoid progenitors and beyond, they can be identified by certain cell surface markers using flow cytometry. CD34, for example, is a marker present on all hematopoietic stem cells. Other CD markers may be present only on myeloid stem cells and not on lymphoid stem cells, and vice versa, even when the cells morphologically look the same (this is often used to classify types of leukemias). We’ll learn more about CD markers (these are used a lot in flow cytometry to identify cells) later. However, when doing bone marrow transplant, we use CD34 to identify and quantify hematopoietic stem cells, to ensure that we are transplanting adequate numbers of actual stem cells into a bone marrow transplant recipient patient.
Stem cell fate is determined by both intrinsic and extrinsic factors. These factors are important for driving cell differentiation (as opposed to cell self-renewal), and production. The bone marrow environment is rich in factors to help stem cells survive/thrive/differentiate, etc. The textbook and your lecture slides today review this nicely.
Bone Marrow Failure
Stem cells can fail. By this we mean that stem cells can be destroyed or stop functioning/stop making cells. This is a life-threatening health event and can be very challenging to treat. Complete bone marrow failure will result in pancytopenia (lack of white blood cells, red blood cells and platelets).
Causes of bone marrow/stem cell failure:
- Autoimmune disorders/acquired immune dysregulation can lead to complete bone marrow failure, as can other acquired causes. Complete bone marrow failure is called aplastic anemia, but this is more than just anemia. Despite the name “aplastic anemia”, this disorder is defined by pancytopenia–production of all cell lines (WBC, RBC, and platelets) is disrupted. Bone marrow testing in patients with aplastic anemia will demonstrate a hypocellular bone marrow without an abnormal infiltrate of other cells and without marrow fibrosis.
- Inherited genetic disorders can result in bone marrow failure (one example is Fanconi Anemia).
- Extrinsic insults to the bone marrow such as toxins (chemotherapy, alcohol, other poisons) and radiation can cause bone marrow to fail.
- Damage to the genome of stem cells may either cause defects that impair proliferation and differentiation or induce formation of neoantigens that trigger immune destruction.
Aplastic anemia is a clinical-pathologic diagnosis that requires both of the following:
- Bone marrow hypoplasia/aplasia without an infiltrative process
-
The presence of ≥2 of the following cytopenia findings:
-
Reticulocytes <40,000/µL (or <1%)
-
ANC <500/µL
-
Platelets <20,000/µL
-
Optional text book reading: Part 1 Anemia and Red Cell Disorders
Chapter 4: Anemias due to bone marrow failure or infiltration
Clinical features: Patients with aplastic anemia typically present with symptoms of pancytopenia, including fatigue and dyspnea (anemia), infections and fever (neutropenia), and mucosal bleeding or petechiae (thrombocytopenia). Infections are often bacterial; severe neutropenia increases the risk of invasive fungal infections. Some cases are asymptomatic and are detected via abnormal laboratory blood counts, including complete blood count (CBC), reticulocyte count, and bone marrow biopsy.
Immune-mediated aplastic anemia: In immune mediated aplastic anemia, there is an acquired immune attack against normal HSC. Autoreactive T-helper lymphocytes (T1) secrete cytokines (eg, IFN-γ and TNF), thus triggering the apoptotic pathway in hematopoietic stem cells. This observation supports the theory that immunosuppressive treatments targeting T-cells (including antithymocyte globulin) have demonstrated effectiveness for many patients. In about 50-60% of cases of aplastic anemia, a small population of HSC with loss of GPI anchors can be identified. These GPI negative cells may be spared from immune attack, allowing for their survival. The underlying mutation that contributes to GPI negative stem and progenitor cells is in the X-linked gene PIGA, which is involved in the first step of GPI biosynthesis. Loss of GPI anchored complement regulatory proteins on RBC (CD55 and CD59), as well as other GPI anchored proteins, can be identified using flow cytometry testing.
Optional text book reading: Part 1 Anemia and Red Cell Disorders
Chapter 11: Acquired hemolytic anemias (brief section on PNH- acquired membrane disorders)
Stem Cell Clonal Progression (A concept you need to know)
Stem cells, because they are constantly dividing, can acquire DNA mutations. Not all mutations in a stem cell cause failure of that stem cell. Mutations can have negative or positive effects on the ability of a stem cell to replicate and differentiate. It is important to note that if mutations occur in replicating stem cells that give those mutated stem cells an advantage to replicate or differentiate better or faster than other stem cells, one can develop clonal progression of those mutated stem cells. Over time, with clonal progression/proliferation of those stem cells, they may produce most of the final hematopoietic cells, as they take over a large percentage of the bone marrow cell production due to the selective advantage in replication that their mutation gives them. This is the concept of clonal progression.
Clonal expansion of Hematopoietic Stem cells can be seen in various clinical settings, including the following scenarios:
- Aging.
- Bone marrow engraftment and recovery after hematopoietic stem cell transplantation.
- Bone marrow recovery after cytotoxic chemotherapy.
- Aplastic Anemia recovery (after treatments).
- Certain inherited cancer predisposition syndromes
- Acquired mutations in bone marrow stem cells that give them a selective advantage—example is Paroxysmal Nocturnal Hemoglobinuria (PNH).
We believe clonal progression is ultimately the cause of many blood cancers and other bone marrow disorders. Acquired mutations in these replicating cells (remember, your bone marrow is making billions of cells a day) can result in mutations leading to myelodysplastic syndrome (more on this later) and acute leukemias. The longer we live, the more likely we are to have these types of acquired mutations. This is why myelodysplastic syndrome is generally a disease of older adults.
Hematopoietic Growth Factors and Their Effects on Hematopoiesis
There are growth factors involved in differentiation and maturation of different progenitor cells into mature red blood cells, white blood cells, and platelets. It is important to know that while there are many growth factors involved in bone marrow cell production, there are 3 growth factors that are lineage specific for Red blood cells, White blood cells, or platelets. These growth factors, produced normally in the human body, can also be synthetically produced and now are manufactured and used as treatments in certain settings of low red blood cells, low white blood cells, or low platelets. These factors are on your drug list as well, and are as follows:
- Erythropoietin (EPO): EPO stimulates Red blood cell production. EPO is produced in the body mainly by the kidney in adults. It is common for patients with chronic renal failure to have anemia due to low EPO production. The classic pharmaceutical drug used to treat anemia in certain clinical settings (such as anemia due to renal failure) is epoetin alfa.
- Granulocyte stimulating factor (G-CSF): G-CSF stimulates production of granulocytes/neutrophils. G-CSF is produced by activated monocytes, macrophages, endothelial cells and fibroblasts in the bone marrow. The classic pharmaceutical drug used in the clinical setting is filgrastim, and this is commonly used to stimulate production of neutrophils to aid in bone marrow recovery after chemotherapy is given.
- Thrombopoietin (TPO): TPO stimulates production of platelets and is naturally produced by the liver, kidney, and skeletal muscle. Pharmaceutical drugs that have been developed that act like endogenous TPO include romiplostim and eltrombopag (TPO receptor agonists). These drugs are used to treat disorders such as thrombocytopenia due to immune destruction (immmune-mediated thrombocytopenia). Eltrombopag is also effective in the treatment of aplastic anemia, since TPO has a role in HSC survival. That is not the case for EPO or GCSF and thus these growth factors are not effective treatments for aplastic anemia . Advanced liver disease is associated with low platelet levels in part due to reduced hepatic-TPO synthesis.
Optional textbook reading: Part 1 Anemia and Red Cell Disorders
Chapter 2: Hematopoiesis (section on control of myelopoiesis by growth factors)
Stem Cell Transplant
We now move on to discuss the role of hematopoietic stem cell transplant. When a patient’s bone marrow fails it is possible to transplant bone marrow stem cells from a healthy donor to repopulate a patient’s failed bone marrow. This is the concept behind a bone marrow transplant or stem cell transplant. Stem cell transplants can be used in other settings as well. A stem cell transplant can be used, for example, after we deliver high doses of chemotherapy to eliminate residual cancer cells in patient. We then restore the patient’s marrow with their own or another donor’s stem cells that are transplanted into the patient. In the case of a patient receiving their own stem cells, such cells are harvested from the patient prior to giving them chemotherapy that will destroy their residual bone marrow. In the case of donor cells for a patient derived from a different healthy donor (allogeneic transplant) there is also the added benefit of a graft vs disease effect, which does not happen when a patient’s own stem cells are used (autologous transplant). The transplanted stem cells home to the marrow and restore hematopoiesis following a ‘conditioning’ regimen which allows for stem cell engraftment. We use bone marrow stem cells to treat blood diseases in various clinical settings.
A clarification on terminology: When bone marrow transplant first came out as a treatment option, bone marrow stem cells were directly harvested from a stem cell donor’s bone marrow by repeatedly putting needles through the skin into their bone marrow in their pelvis bones, aspirating out this bone marrow into syringes, then putting this liquid marrow in a basin to be processed/stored. This procedure required the person donating stem cells to be under anesthesia in the operating room while this procedure was done. As we have advanced our technology and understanding of bone marrow stem cells, we have discovered that certain stimulating factors (including synthetic G-CSF) will cause stem cells in bone marrow to be released from the bone marrow and circulate in peripheral blood, where they can then be collected from stem cell donors by a process called apheresis—a process which is similar to dialysis. Obviously, this is a much less invasive procedure to collect stem cells, and stem cell donors generally prefer this method. Interestingly, stem cells derived directly from the bone marrow have slightly different qualities than stem cells collected via apheresis, although both are excellent sources for stem cells for bone marrow transplants. Sometimes the term “bone marrow stem cells” is meant to imply stem cells taken directly from a donor’s bone marrow, while “peripheral stem cells” refers to stem cells collected from peripheral blood of a donor by apheresis. For this course, we will use the terms “stem cell transplant” and “bone marrow transplant” interchangeably.
There are 2 types of bone marrow stem cell transplants, also known as bone marrow transplants:
- Autologous stem cell transplant: Hematopoietic stem cells are collected from the patient and stored for future use to give back to the same patient. This is usually done when a patient requires a treatment for cancer that involves high doses of chemotherapy. Such high doses of chemotherapy can kill the cancer cells, but unfortunately may also kill the patient’s bone marrow. After the patient’s stem cells are collected and stored (usually at a blood bank), then the patient is given chemotherapy to wipe out their cancer. After the chemotherapy is out of their system (generally 24 hours later) and has done its damage to the cancer (but also has happened to damage the patient’s current stem cells in their bone marrow), then the stored stem cells (that were taken out before the patient was given chemotherapy and hence have not been damaged by that chemotherapy) are re-infused to repopulate the bone marrow to overcome the chemotherapy toxicity.
- Allogeneic stem cell transplant: Hematopoietic stem cells are collected from a donor (not the patient). These cells are stored and then later infused into a patient to replace that patient’s bone marrow (presumably their bone marrow has failed or has been destroyed by chemotherapy, etc). These stem cells from the donor will repopulate the patient’s marrow such that they engraft and then start producing more differentiated blood cell precursors and ultimately produce mature blood cells (RBCs, WBCs, and platelets). Because the stem cells come from a donor, the lymphocytes that the donor bone marrow produces in the bone marrow recipient can see the recipient’s other tissues as “foreign”. This results in some autoimmune issues, as the stem cells from the donor can see and attack the patient’s own cells (this is called graft vs host disease and causes problems for the patient). These lymphocytes that result from the stem cells from the donor also can attack any residual cancer cells in the patient (graft vs leukemia effect) which is a good thing and can reduce risk of relapse of leukemia in such a patient. Allogeneic stem cell transplants are commonly used to treat patients with acute leukemia, as such patients don’t have normal stem cells to begin with and thus aren’t good candidates for autologous stem cell transplant.

Alternative “stem cell” therapies: You will hear about stem cell replacements done for other health problems, which are generally not referring to bone marrow stem cell transplant. These types of “stem cell therapies” offered in a number of locations are not the same as the stem cell transplants we are talking about in this course and patients should be counseled that these are unproven treatments, with potential harms.
A third source of stem cells: As previously mentioned, stem cells for transplant to replace bone marrow stem cells can either be taken directly from the bone marrow (harvested from bone marrow), which requires a surgical procedure for the donor done in the operating room or they can be harvested from the peripheral blood of the donor using a procedure called apheresis (which is similar to dialysis). Stem cells for bone marrow replacement can also be obtained from donated human placenta cord blood.
Diseases treated with hematopoietic stem cell transplant include the following:
Autologous stem cell transplant:
- Lymphoma
- Myeloma
- some Autoimmune diseases.
Allogeneic stem cell transplant:
- Certain genetic disorders such as Sickle cell anemia, Thalassemia, Fanconi Anemia
- Aplastic Anemia
- Malignancies such as Acute Leukemias (both lymphoblastic and myeloblastic acute leukemias), and some lymphomas.
Authors and Contributors:
Corliss Newman, MD authored this course pack material to correspond to lecture slides covering the Overview of Hematopoiesis available on Canvas. Kristi Rice, MD and Nicholas Burwick, MD provided editing assistance.